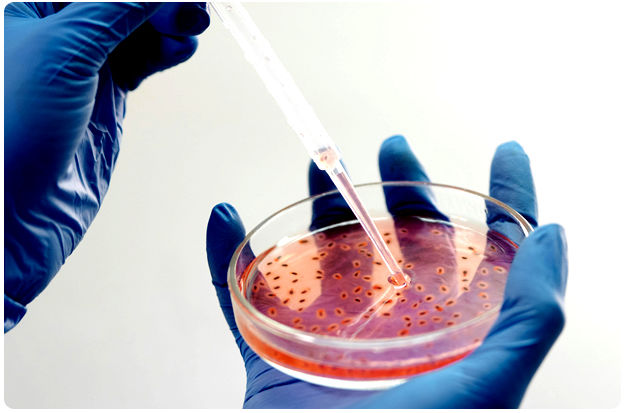

We also focus on critical examination of immune related pathologies of the human body system.
At our facility, we go beyond conventional diagnostics to prioritize the critical examination of immune-related pathologies within the human body system. With a dedicated focus on understanding the intricate workings of the immune system, our expert team utilizes advanced methodologies and cutting-edge technology to meticulously analyze immune-related disorders.
From autoimmune diseases to immunodeficiency conditions, we delve deep into the underlying mechanisms, providing comprehensive insights for accurate diagnosis and tailored treatment strategies. By staying at the forefront of immunology research, we aim to empower patients with the knowledge and resources needed to effectively manage their immune health. Trust us for thorough examination and compassionate care, ensuring optimal outcomes for every individual.